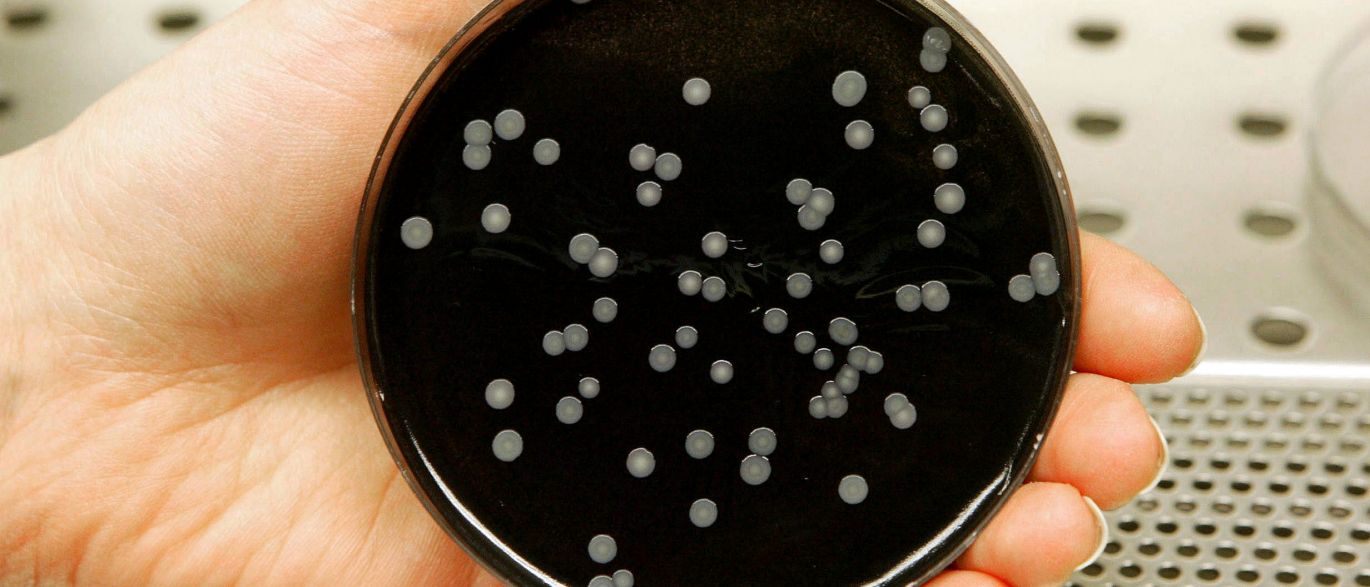

Hotel evacuado por suspeitas de Legionella
Caso não tem relação com os outros 12 registados no Norte do país.
2015-09-05 16:56:24 - (68 visualizações)
Uma unidade hoteleira do Porto foi evacuada por suspeitas de Legionella, avança o Jornal de Notícias.
Os hóspedes começaram a abandonar o Hotel Boa-vista, na Foz do Douro, esta sexta-feira à noite por se suspeitar que a rede de água do estabelecimento possa estar contaminada com a bactéria.
O mesmo jornal dá conta de que estão a ser feitas análise e que não há, por enquanto, indícios de que alguém tenha contraído a doença do legionário.
Os “organismos oficiais tomaram as devidas precauções, devido aos indícios de epidemia na zona ocidental da cidade”, contou o diretor do Hotel Boa-vista ao JN.
Já o diretor-geral da Saúde, Francisco George, salvaguardou que este caso não tem relação com os 12 outros casos de Legionella registados na região Norte do país
Fonte: http://www.noticiasaominuto.pt